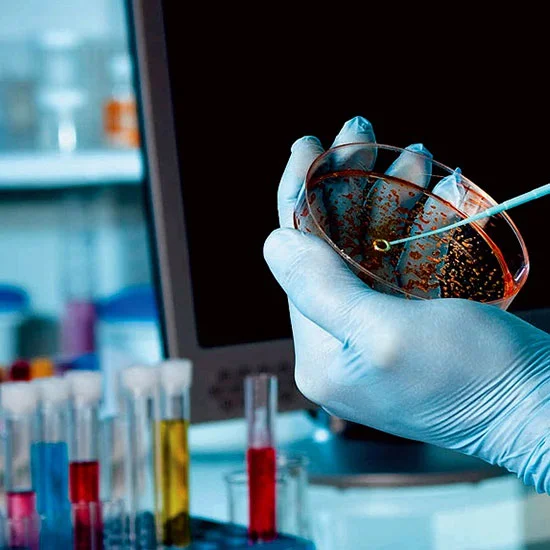

Pathology Lab
Baleni Diagnostic Center & Imaging Center?
Pathology Expertise at Baleni Diagnostics Center
Baleni Diagnostics Center, located in Haridwar, is a trusted pathology and diagnostic laboratory offering a wide range of accurate and reliable testing services. Known for its commitment to precision, quality standards, and patient-focused care, the center provides dependable diagnostic support for doctors and patients alike.
Baleni Diagnostics Center recognizes pathology as a cornerstone of modern healthcare. Through advanced laboratory testing and analysis, pathology plays a vital role in the early detection, diagnosis, and monitoring of diseases. Using modern equipment and standardized procedures, our pathology lab delivers safe, accurate, and timely results for various medical evaluations, including:
Routine Blood Tests
Complete Blood Count (CBC), blood sugar, lipid profile, and other essential tests for general health monitoring.
Biochemistry Tests
Liver function tests (LFT), kidney function tests (KFT), electrolytes, and metabolic assessments.
Urine & Stool Analysis
Tests to detect infections, metabolic disorders, and digestive health issues.
Hormonal & Specialized Tests
Thyroid profile, hormone analysis, and other specialized pathology investigations.
Benefits of Choosing Baleni Diagnostic Center for Pathology Services
Baleni Diagnostics Center offers several advantages when considering a mammography examination:
Accurate & Reliable Results
Our advanced digital mammography equipment ensures precise imaging for confident diagnoses.
Wide Range of Tests
Comprehensive pathology services including blood tests, biochemistry, urine analysis, and specialized investigations.
Experienced & Compassionate Team
Our skilled radiologists and staff prioritize patient comfort and provide expert guidance throughout the process.
Patient-Focused Care
Hygienic sample collection, courteous staff, and a comfortable testing environment.
Our pathology services are designed to meet the diverse diagnostic needs of our patients, ranging from routine laboratory tests to detailed diagnostic evaluations. We use advanced laboratory technology and standardized testing procedures to ensure accurate sample analysis, enabling our expert team to deliver precise results and timely reports.
What truly sets us apart is our commitment to patient-centered care. We focus on patient comfort, hygiene, and convenience throughout the entire testing process — from sample collection to report delivery. Our friendly and experienced staff are always available to answer your questions and ensure your experience at Baleni Diagnostics Lab is smooth, reliable, and stress-free.
REQUEST A CALL
We call you back
While Baleni Diagnostic Center & Imaging Centre currently does not offer online appointment booking, you can contact the center directly by phone to schedule your visit.
TALK TO A SPECIALIST
Let's Talk Business
While Baleni Diagnostic Center & Imaging Centre currently does not offer online appointment booking, you can contact the center directly by phone to schedule your visit.
- 7895363232
- www.balenidiagnosticccenter@gmail.com
- D-59 Shivalik nagar, Haridwar
